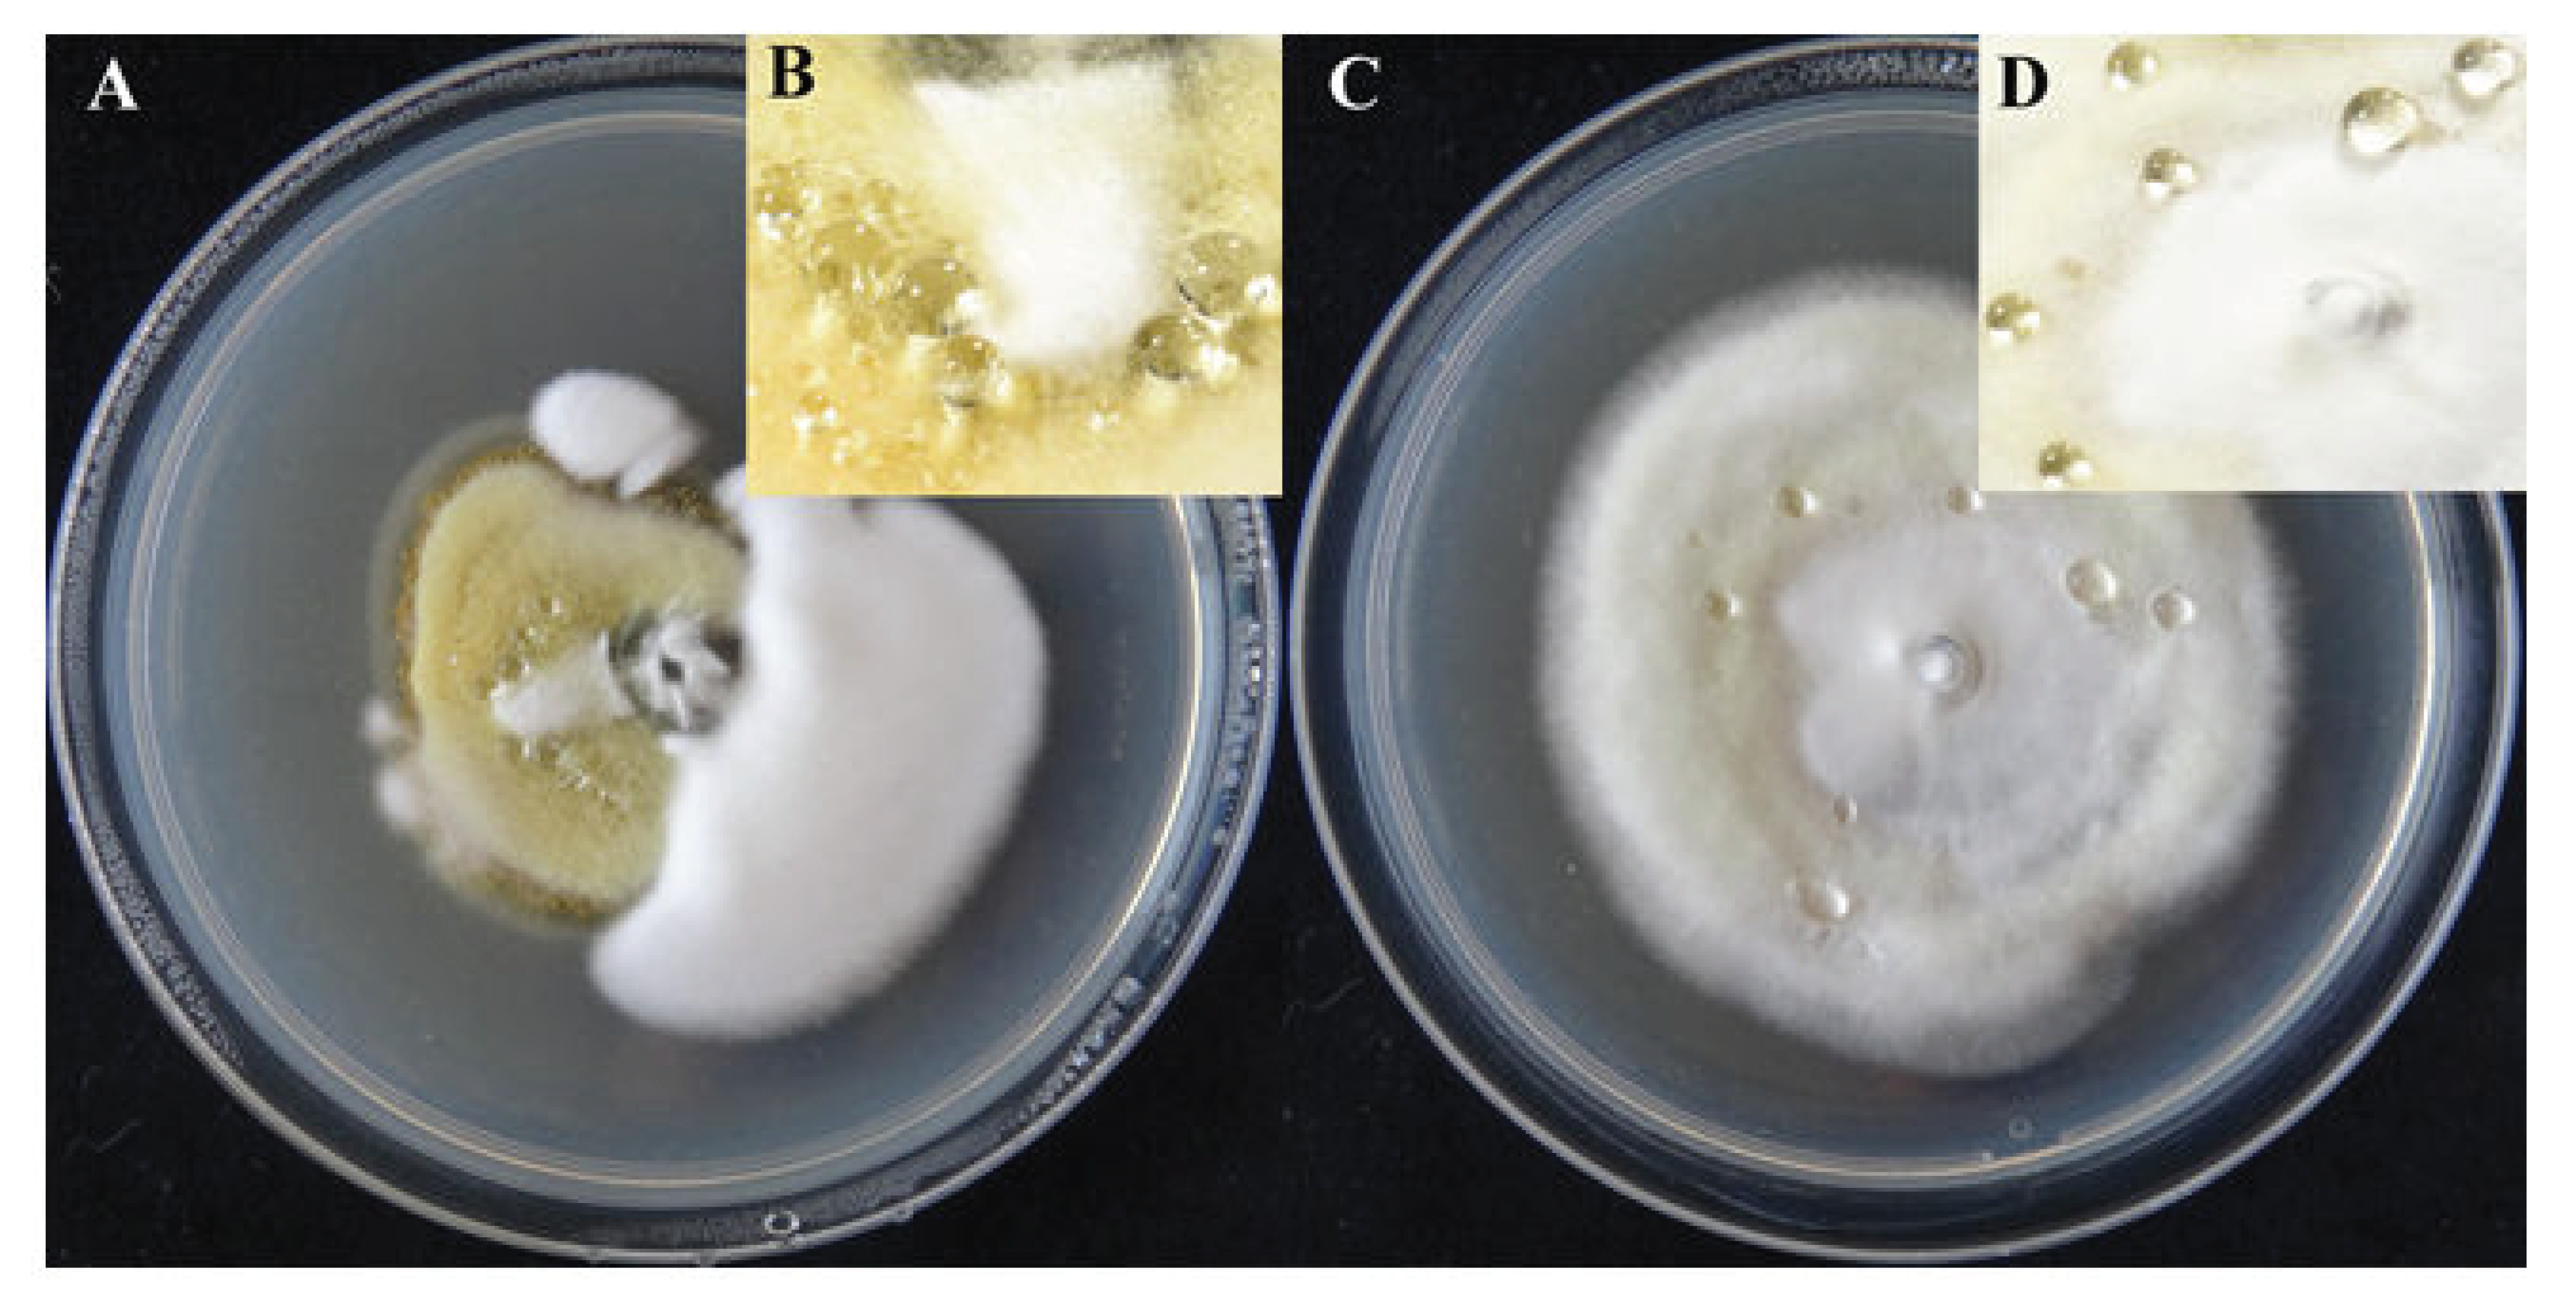

Proteomic Analysis of Mycelial Exudates of Ustilaginoidea virens
Abstract
1. Introduction
2. Results
2.1. Colony and Exudate Morphology of U. virens
2.2. Protein Identification
2.3. GO Classification
2.4. KEGG Pathway Analysis
2.5. Protein–Protein Interaction (PPI) Network Analysis
3. Discussion
4. Materials and Methods
4.1. Fungal and Exudate Materials
4.2. Enzymatic Hydrolysis of Proteins
4.3. LC-MS/MS Analysis
4.4. Sequence Database Searching
4.5. Bioinformatic Analysis
Supplementary Materials
Author Contributions
Funding
Institutional Review Board Statement
Informed Consent Statement
Data Availability Statement
Acknowledgments
Conflicts of Interest
References
- Andargie, M.; Li, J.X. Arabidopsis thaliana: A model host plant to study plant-pathogen interaction using rice false smut isolates of Ustilaginoidea virens. Front. Plant Sci. 2016, 7, 192. [Google Scholar] [CrossRef]
- Zhang, N.; Yang, J.Y.; Fang, A.F.; Wang, J.Y.; Li, D.Y.; Li, Y.J.; Wang, S.Z.; Cui, F.H.; Yu, J.J.; Liu, Y.F.; et al. The essential effector SCRE1 in Ustilaginoidea virens suppresses rice immunity via a small peptide region. Mol. Plant Pathol. 2020, 21, 445–459. [Google Scholar] [CrossRef] [PubMed]
- Cooke, M.C. Some extra-European fungi. Grevillea 1878, 7, 13–15. [Google Scholar]
- Ladhalakshmi, D.; Srinivas Prasad, M.; Prakasam, V.; Krishnaveni, D.; Sailaja, B.; Ram, S.; Vindeswari, P.; Jagjeet Singh, L.; Jyoti, J.; Surendran, M.; et al. Geographic distribution of false smut disease of rice in India and efficacy of selected fungicides for its management. Int. J. Pest Manag. 2019, 65, 177–185. [Google Scholar] [CrossRef]
- Andargie, M.; Li, L.Y.; Feng, A.Q.; Zhu, X.Y.; Li, J.X. Development of a GFP-expressing Ustilaginoidea virens strain to study fungal invasion and colonization in rice spikelets. S. Afr. J. Bot. 2015, 97, 16–24. [Google Scholar] [CrossRef]
- Hiremath, S.S.; Bhatia, D.; Jain, J.; Hunjan, M.S.; Kaur, R.; Zaidi, N.W.; Singh, U.S.; Zhou, B.; Lore, J.S. Identification of potential donors and QTLs for resistance to false smut in a subset of rice diversity panel. Eur. J. Plant Pathol. 2020. [Google Scholar] [CrossRef]
- Fan, J.; Yang, J.; Wang, Y.Q.; Li, G.B.; Li, Y.; Huang, F.; Wang, W.M. Current understanding on Villosiclava virens, a unique flower-infecting fungus causing rice false smut disease. Mol. Plant Pathol. 2016, 17, 1321–1330. [Google Scholar] [CrossRef] [PubMed]
- Andargie, M.; Li, J. Expression of the Arabidopsis SWEET genes during rice false smut infection in the transgenic Arabidopsis thaliana containing increased levels of ATP and sucrose. Curr. Plant Biol. 2019. [Google Scholar] [CrossRef]
- Brooks, S.A.; Anders, M.M.; Yeater, K.M. Effect of furrow irrigation on the severity of false smut in susceptible rice varieties. Plant Dis. 2010, 94, 570–574. [Google Scholar] [CrossRef]
- Fan, L.L.; Yong, M.L.; Li, D.Y.; Liu, Y.J.; Lai, C.H.; Chen, H.M.; Cheng, F.M.; Hu, D.W. Effect of temperature on the development of sclerotia in Villosiclava virens. J. Integr. Agric. 2016, 15, 2550–2555. [Google Scholar] [CrossRef]
- Yong, M.L.; Deng, Q.D.; Fan, L.L.; Miao, J.K. The role of Ustilaginoidea virens sclerotia in increasing incidence of rice false smut disease in the subtropical zone in China. Eur. J. Plant Pathol. 2018, 150, 669–677. [Google Scholar] [CrossRef]
- Singh, A.K.; Pophaly, D.J. An unusual rice false smut epidemic reported in Raigarh District, Chhattisgarh, India. Int. Rice Res. 2010, 35, 1–3. [Google Scholar]
- Wang, X.H.; Wang, J.; Lai, D.W.; Wang, W.X.; Dai, J.G.; Zhou, L.G.; Liu, Y. Ustiloxin G, a new cyclopeptide mycotoxin from rice false smut balls. Toxins 2017, 9, 54. [Google Scholar] [CrossRef] [PubMed]
- Sun, W.X.; Fan, J.; Fang, A.F.; Li, Y.J.; Tariqjaveed, M.; Li, D.Y.; Hu, D.W.; Wang, W.M. Ustilaginoidea virens: Insights into an emerging rice pathogen. Annu. Rev. Phytopathol. 2020, 58, 363–385. [Google Scholar] [CrossRef]
- Koiso, Y.; Li, Y.; Iwasaki, S.; Hanaka, K.; Kobayashi, T.; Sonoda, R.; Yaegashi, H.; Sato, Z. Ustiloxins, antimitotic cyclic peptides from false smut balls on rice panicles caused by Ustilaginoidea virens. J. Antibiot. 1994, 47, 765–773. [Google Scholar] [CrossRef]
- Liang, Y.; Strelkov, S.E.; Kav, N.N.V. The proteome of liquid Sclerotial exudates from Sclerotinia sclerotiorum. J. Proteome Res. 2010, 9, 3290–3298. [Google Scholar] [CrossRef]
- Wang, D.; Fu, J.F.; Zhou, R.J.; Li, Z.B.; Xie, Y.J. Proteomics research and related functional classification of liquid sclerotial exudates of Sclerotinia ginseng. PeerJ 2017, 5, e3979. [Google Scholar] [CrossRef] [PubMed]
- Wang, H.N.; Wei, S.H.; Yang, X.H.; Liu, W.; Zhu, L.J. Proteomic analysis of exudate of Cercospora armoraciae from Armoracia rusticana. PeerJ 2020, 8, e9592. [Google Scholar] [CrossRef] [PubMed]
- Pandey, M.K.; Sarma, B.K.; Singh, D.P.; Singh, U.P. Biochemical investigations of sclerotial exudates of Sclerotium rolfsii and their antifungal activity. J. Phytopathol. 2007, 155, 84–89. [Google Scholar] [CrossRef]
- Aliferis, K.A.; Jabaji, S. Metabolite Composition and Bioactivity of Rhizoctonia solani Sclerotial Exudates. J. Agric. Food Chem. 2010, 58, 7604–7615. [Google Scholar] [CrossRef] [PubMed]
- Colotelo, N. Chemical studies on the exudate and developing sclerotia of Sclerotinia sclerotiorum (Lib.) De Bary. Can. J. Microbiol. 1971, 17, 1189–1194. [Google Scholar] [CrossRef]
- Colotelo, N. Physiological and biochemical properties of the exudate associated with developing sclerotia of Sclerotinia sclerotiorum (Lib.) De Bary. Can. J. Microbiol 1973, 19, 73–79. [Google Scholar] [CrossRef]
- Moore, A.E.P. Reserve substances in Paxillus involutus sclerotia determined by histochemistry and X-ray microanalysis. Protoplasma 1991, 163, 67–81. [Google Scholar] [CrossRef]
- Singh, U.P.; Sarma, B.K.; Singh, D.P.; Bahadur, A. Studies on exudate-depleted sclerotial development in Sclerotium rolfsii and the effect of oxalic acid, sclerotial exudate, and culture filtrate on phenolic acid induction in chickpea (Cicer arietinum). Can. J. Microbiol. 2002, 48, 443–448. [Google Scholar] [CrossRef] [PubMed]
- Wang, D.; Fu, J.F.; Zhou, R.J.; Li, Z.B.; Xie, Y.J.; Liu, X.R.; Han, Y.L. Formation of sclerotia in Sclerotinia ginseng and composition of the sclerotial exudate. PeerJ 2018, 6, e6009. [Google Scholar] [CrossRef]
- Cooke, R.C. Changes in soluble carbohydrates during sclerotium formation by Sclerotinia sclerotiorum and S. trifoliorum. Trans. Br. Mycol. Soc. 1969, 53, 77–86. [Google Scholar] [CrossRef]
- Willetts, H.J.; Bullock, S. Developmental biology of sclerotia. Mycol. Res. 1992, 96, 801–816. [Google Scholar] [CrossRef]
- Rani, R.; Sharma, V.K.; Pannu, P.P.S.; Lore, J.S. Influence of nitrogen fertilizer dose on false smut of rice (Oryza sativa) caused by Ustilaginoidea virens. Indian J. Agric. Sci. 2015, 85, 1003–1006. [Google Scholar]
- Tang, Y.X.; Jin, J.; Hu, D.W.; Yong, M.L.; Xu, Y.; He, L.P. Elucidation of the infection process of Ustilaginoidea virens (teleomorph: Villosiclava virens) in rice spikelets. Plant Pathol. 2013, 62, 1–8. [Google Scholar] [CrossRef]
- Fu, R.T.; Yin, C.C.; Liu, Y.; Ding, L.; Zhu, J.; Zheng, A.P.; Li, P. The influence of nutrient and environmental factors on mycelium growth and conidium of false smut Villosiclava virens. Afr. J. Microbiol. Res. 2013, 7, 825–833. [Google Scholar] [CrossRef]
- Anasontzis, G.E.; Lebrun, M.H.; Haon, M.; Champion, C.; Kohler, A.; Lenfant, N.; Martin, F.; O′Connell, R.J.; Riley, R.; Grigoriev, I.V.; et al. Broad-specificity GH131 β-glucanases are a hallmark of fungi and oomycetes that colonize plants. Environ. Microbiol. 2019, 21, 2724–2739. [Google Scholar] [CrossRef]
- Adams, D.J. Fungal cell wall chitinases and glucanases. Microbiology 2004, 150, 2029–2035. [Google Scholar] [CrossRef] [PubMed]
- Andoni, R.G.; Aize, P.; Idoia, B.; Aitziber, A.; Aitana, A.D.; Xabier, G.; Aitor, R.; Fernando, L.H. Proteomics as a Tool to Identify New Targets Against Aspergillus and Scedosporium in the Context of Cystic Fibrosis. Mycopathologia 2018, 183, 273–289. [Google Scholar] [CrossRef]
- Pardini, G.; De Groot, P.W.J.; Coste, A.T.; Karababa, M.; Klis, F.M.; de Koster, C.G.; Sanglard, D. The CRH family coding for cell wall glycosylphosphatidylinositol proteins with a predicted transglycosidase domain affects cell wall organization and virulence of Candida albicans. J. Biol. Chem. 2006, 281, 40399–40411. [Google Scholar] [CrossRef]
- Teparić, R.; Stuparević, I.; Mrsa, V. Increased mortality of Saccharomyces cerevisiae cell wall protein mutants. Microbiology 2004, 150, 3145–3150. [Google Scholar] [CrossRef] [PubMed]
- Damveld, R.A.; Arentshorst, M.; VanKuyk, P.A.; Klis, F.M.; van den Hondel, C.A.M.J.J.; Ram, A.F.J. Characterisation of CwpA, a putative glycosylphosphatidylinositol-anchored cell wall mannoprotein in the filamentous fungus Aspergillus niger. Fungal Genet. Biol. 2005, 42, 873–885. [Google Scholar] [CrossRef]
- Ciamak, G. Molecular Insights into Pathogenesis and Infection with Aspergillus Fumigatus. Malays. J. Med Sci. 2017, 24, 10–20. [Google Scholar] [CrossRef]
- Galagan, J.E.; Calvo, S.E.; Borkovich, K.A.; Selker, E.U.; Read, N.D.; Jaffe, D.; FitzHugh, W.; Ma, L.J.; Smirnov, S.; Purcell, S.; et al. The genome sequence of the filamentous fungus Neurospora crassa. Nature 2003. [Google Scholar] [CrossRef]
- Husaini, A.M.; Morimoto, K.; Chandrasekar, B.; Kelly, S.; Kaschani, F.; Palmero, D.; Jiang, J.B.; Kaiser, M.; Ahrazem, O.; Overkleeft, H.S.; et al. Multiplex fluorescent, activity-based protein profiling identifies active α-Glycosidases and other hydrolases in plants. Plant Physiol. 2018, 177, 24–37. [Google Scholar] [CrossRef] [PubMed]
- Brul, S.; King, A.; van der Vaart, J.M.; Chapman, J.; Klis, F.; Verrips, C.T. The incorporation of mannoproteins in the cell wall of S. cerevisiae and filamentous Ascomycetes. Antonie Van Leeuwenhoek 1997, 72, 229–237. [Google Scholar] [CrossRef]
- Pietrella, D.; Bistoni, G.; Corbucci, C.; Perito, S.; Vecchiarelli, A. Candida albicans mannoprotein influences the biological function of dendritic cells. Cell. Microbiol. 2006, 8, 602–612. [Google Scholar] [CrossRef]
- Eades, C.J.; Hintz, W.E. Characterization of the Class I α-mannosidase gene family in the filamentous fungus Aspergillus nidulans. Gene 2000, 255, 25–34. [Google Scholar] [CrossRef]
- Da Mota, P.R.; Ribeiro, M.S.; de Castro Georg, R.; Silva, G.R.; de Paula, R.G.; do Nascimento Silva, R.; Ulhoa, C.J. Expression analysis of the α-1,2-mannosidase from the mycoparasitic fungus Trichoderma harzianum. Biol. Control 2016, 95, 1–4. [Google Scholar] [CrossRef]
- Johnsen, M.G.; Hansen, O.C.; Stougaard, P. Isolation, characterization and heterologous expression of a novel chitosanase from Janthinobacterium sp. strain 4239. Microb. Cell Factories 2010, 9, 5–13. [Google Scholar] [CrossRef] [PubMed]
- Nguyen, A.D.; Huang, C.C.; Liang, T.W.; Nguyen, V.B.; Pan, P.S.; Wang, S.L. Production and purification of a fungal chitosanase and chitooligomers from Penicillium janthinellum D4 and discovery of the enzyme activators. Carbohydr. Polym. 2014, 108, 331–337. [Google Scholar] [CrossRef] [PubMed]
- Choi, C.J.; Ju, H.J.; Park, B.H.; Qin, R.; Jahng, K.Y.; Han, D.M.; Chae, K.S. Isolation and characterization of the Aspergillus nidulans eglC gene encoding a putative beta-1,3-endoglucanase. Fungal Genet. Biol. 2005, 42, 590–600. [Google Scholar] [CrossRef]
- Kamei, M.; Yamashita, K.; Takahashi, M.; Fukumori, F.; Ichiishi, A.; Fujimura, M. Deletion and expression analysis of beta-(1,3)-glucanosyltransferase genes in Neurospora crassa. Fungal Fenetics Biol. 2013, 52, 65–72. [Google Scholar] [CrossRef]
- Mouyna, I.; Morelle, W.; Vai, M.; Monod, M.; Lechenne, B.; Fontaine, T.; Beauvais, A.; Sarfati, J.; Prevost, M.C.; Henry, C.; et al. Deletion of GEL2 encoding for a [beta](1-3)glucanosyltransferase affects morphogenesis and virulence in Aspergillus fumigatus. Mol. Microbiol. 2005, 56, 1675–1688. [Google Scholar] [CrossRef]
- Luo, Z.B.; Zhang, T.B.; Liu, P.F.; Bai, Y.T.; Chen, Q.Y.; Zhang, Y.J.; Keyhani, N.O. The Beauveria bassiana Gas3 beta-Glucanosyltransferase contributes to fungal adaptation to extreme alkaline conditions. Appl. Environ. Microbiol. 2018, 84. [Google Scholar] [CrossRef] [PubMed]
- Schatzman, S.; Teka, M.; Peterson, R.; Cabelli, D.; Culotta, V. 27-The Irony of Cu-only superoxide dismutases in fungal pathogens. Free Radic. Biol. Med. 2017, 112, 33. [Google Scholar] [CrossRef]
- Gleason, J.E.; Galaleldeen, A.; Peterson, R.L.; Taylor, A.B.; Holloway, S.P.; Waninger-Saroni, J.; Cormack, B.P.; Cabelli, D.E.; Hart, P.J.; Culotta, V.C. Candida albicans SOD5 represents the prototype of an unprecedented class of Cu-only superoxide dismutases required for pathogen defense. Proc. Natl. Acad. Sci. USA 2014, 111, 5866–5871. [Google Scholar] [CrossRef]
- Kubicek, C.P.; Starr, T.L.; Glass, N.L. Plant cell wall-degrading enzymes and their secretion in plant-pathogenic fungi. Annu. Rev. Phytopathol. 2014, 52, 427–451. [Google Scholar] [CrossRef] [PubMed]
- Hong, T.Y.; Meng, M. Biochemical characterization and antifungal activity of an endo-1,3-β-glucanase of Paenibacillus sp. isolated from garden soil. Appl. Microbiol. Biotechnol. 2003, 61, 472–478. [Google Scholar] [CrossRef] [PubMed]
- Scheiblbrandner, S.; Ludwig, R. Cellobiose dehydrogenase: Bioelectrochemical insights and applications. Bioelectrochemistry 2019, 107345. [Google Scholar] [CrossRef]
- Melin, P.; Schnurer, J.; Wagner, E.G.H. Characterization of phiA, a gene essential for phialide development in Aspergillus nidulans. Fungal Genet. Biol. 2003, 40, 234–241. [Google Scholar] [CrossRef]
- Li, G.H.; Fan, A.; Peng, G.X.; Keyhani, N.; Xin, J.K.; Cao, Y.Q.; Xia, Y.X. A bifunctional catalase-peroxidase, MakatG1, contributes to virulence of Metarhizium acridum by overcoming oxidative stress on the host insect cuticle. Environ. Microbiol. 2017, 19, 4365–4378. [Google Scholar] [CrossRef]
- Alkan, D.; Yemenicioğlu, A. Potential application of natural phenolic antimicrobials and edible film technology against bacterial plant pathogens. Food Hydrocoll. 2016, 55, 1–10. [Google Scholar] [CrossRef]
- Rasheed, N.; Miranda, M.T.P.; Thomas, A.A. Antimicrobial potential of the bacteria associated with Sagrassum wightii against plant fungal pathogen. J. Adv. Sci. Res. 2020, 11, 173–180. [Google Scholar]

| NO a | Protein Functions b | Protein IDs c |
|---|---|---|
| 1 | fungal-type cell wall organization | KDB16044.1, KDB16026.1, KDB12967.1, KDB17270.1, KDB13423.1, KDB12509.1, KDB10968.1, KDB12449.1 |
| 2 | pathogenesis | KDB16026.1, KDB18474.1, KDB18473.1, KDB13423.1, KDB13264.1, KDB17801.1, KDB14282.1, KDB12970.1, KDB12705.1, KDB12369.1, KDB12341.1, KDB12056.1, KDB12863.1, KDB14729.1, KDB12463.1, KDB18714.1, KDB11931.1, KDB11462.1 |
| 3 | response to oxidative stress | KDB14292.1, KDB12590.1, KDB18386.1, KDB17179.1, KDB13850.1, KDB15471.1, KDB13484.1, KDB11596.1, KDB11345.1, KDB11441.1, KDB15626.1, KDB16892.1, KDB13523.1, KDB15731.1, KDB18611.1, KDB16877.1, KDB17534.1 |
| 4 | sporulation resulting in formation of a cellular spore | KDB13075.1, KDB17876.1 |
| 5 | ascospore formation | KDB12701.1, KDB11591.1 |
| 6 | spore germination | KDB17080.1 |
| 7 | cell wall organization | KDB16967.1, KDB18910.1, KDB15368.1, KDB12546.1, KDB14267.1, KDB19043.1, KDB12613.1, KDB14252.1, KDB13987.1, KDB18188.1, KDB11503.1, KDB16319.1 |
| 8 | cellular response to osmotic stress | KDB18447.1, KDB11395.1, KDB13915.1, KDB18874.1, KDB17080.1 |
| 9 | carbohydrate metabolic process | KDB14278.1, KDB18474.1, KDB18473.1, KDB18838.1, KDB14575.1, KDB11829.1, KDB14601.1, KDB14600.1, KDB15368.1, KDB12546.1, KDB11271.1, KDB14684.1, KDB12548.1, KDB15611.1, KDB10889.1, KDB14267.1, KDB14320.1, KDB12419.1, KDB18213.1, KDB13612.1, KDB15373.1, KDB13423.1, KDB11780.1 |
| 10 | cell redox homeostasis | KDB16889.1, KDB12590.1, KDB18386.1, KDB17179.1, KDB18140.1 |
| 11 | cellulose catabolic process | KDB12033.1, KDB16140.1, KDB12252.1, KDB16790.1, KDB11955.1, KDB16468.1, KDB13443.1 |
| 12 | chitin catabolic process | KDB15606.1, KDB11464.1, KDB12586.1 |
| 13 | oxidation–reduction process | KDB16889.1, KDB18474.1, KDB18473.1, KDB17420.1, KDB12801.1, KDB15461.1, KDB12059.1 |
| 14 | filamentous growth | KDB16843.1 |
| 15 | tricarboxylic acid cycle | KDB12786.1, KDB14278.1, KDB14601.1, KDB14600.1, KDB10889.1, KDB13150.1, KDB16991.1, KDB17192.1, KDB16006.1, KDB11543.1, KDB10744.1, KDB14658.1, KDB17818.1, KDB11496.1 |
| 16 | translation | KDB17180.1, KDB17178.1, KDB13202.1, KDB17437.1, KDB17624.1, KDB16501.1, KDB12514.1, KDB15720.1, KDB18497.1, KDB13460.1, KDB12690.1, KDB11557.1, KDB18340.1, KDB13903.1, KDB18121.1, KDB17697.1, KDB12335.1, KDB16500.1, KDB11526.1, KDB11525.1, KDB11907.1, KDB15905.1, KDB16255.1, KDB15436.1, KDB14900.1, KDB13937.1, KDB13450.1, KDB11439.1 |
| 17 | amino acid metabolism process | KDB12840.1, KDB18587.1, KDB14255.1, KDB18363.1, KDB16051.1, KDB18484.1, KDB12951.1, KDB13778.1, KDB13915.1, KDB13888.1, KDB14012.1, KDB14608.1, KDB13578.1, KDB16028.1, KDB11789.1, KDB11862.1, KDB16889.1, KDB16190.1, KDB11291.1, KDB12646.1, KDB11239.1, KDB11321.1, KDB12537.1, KDB18031.1, KDB11222.1, KDB17215.1, KDB15208.1, KDB16374.1, KDB18200.1, KDB16669.1, KDB18959.1, KDB10792.1, KDB18706.1, KDB18773.1, KDB11366.1, KDB11543.1, KDB15471.1, KDB15846.1, KDB12825.1, KDB11677.1, KDB18285.1, KDB12314.1, KDB17813.1, KDB15640.1, KDB16843.1, KDB12482.1, KDB17017.1, KDB11426.1, KDB14889.1, KDB11692.1, KDB13308.1, KDB15264.1, KDB18161.1, KDB15909.1, KDB13150.1, KDB12414.1, KDB13272.1, KDB12151.1 |
| 18 | fatty acid biosynthetic process | KDB13931.1, KDB13929.1, KDB16107.1 |
| 19 | glycolytic process | KDB18218.1, KDB19042.1, KDB15252.1, KDB11157.1, KDB14945.1, KDB14792.1, KDB11877.1, KDB13798.1, KDB18458.1, KDB16050.1, KDB15065.1, KDB10987.1 |
| 20 | defense response to fungus | KDB14422.1, KDB11072.1 |
| 21 | mannose metabolism process | KDB12509.1, KDB13367.1, KDB16099.1, KDB15243.1, KDB13380.1 |
| 22 | response to toxic substance | KDB11815.1 |
| 23 | protein folding | KDB18447.1, KDB13877.1, KDB14801.1, KDB15561.1, KDB18092.1, KDB15388.1, KDB17676.1, KDB15520.1, KDB13738.1, KDB11515.1, KDB17022.1, KDB12004.1, KDB11307.1, KDB11203.1, KDB13922.1 |
| 24 | antibiotic biosynthetic process | KDB15025.1, KDB13507.1, KDB14422.1 |
| 25 | fungal-type cell wall polysaccharide metabolic process | KDB18520.1 |
Publisher’s Note: MDPI stays neutral with regard to jurisdictional claims in published maps and institutional affiliations. |
© 2021 by the authors. Licensee MDPI, Basel, Switzerland. This article is an open access article distributed under the terms and conditions of the Creative Commons Attribution (CC BY) license (http://creativecommons.org/licenses/by/4.0/).
Share and Cite
Wang, H.; Yang, X.; Wei, S.; Wang, Y. Proteomic Analysis of Mycelial Exudates of Ustilaginoidea virens. Pathogens 2021, 10, 364. https://doi.org/10.3390/pathogens10030364
Wang H, Yang X, Wei S, Wang Y. Proteomic Analysis of Mycelial Exudates of Ustilaginoidea virens. Pathogens. 2021; 10(3):364. https://doi.org/10.3390/pathogens10030364
Chicago/Turabian StyleWang, Haining, Xiaohe Yang, Songhong Wei, and Yan Wang. 2021. "Proteomic Analysis of Mycelial Exudates of Ustilaginoidea virens" Pathogens 10, no. 3: 364. https://doi.org/10.3390/pathogens10030364
APA StyleWang, H., Yang, X., Wei, S., & Wang, Y. (2021). Proteomic Analysis of Mycelial Exudates of Ustilaginoidea virens. Pathogens, 10(3), 364. https://doi.org/10.3390/pathogens10030364
